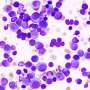

New findings presented at the American Society of Hematology conference in Orlando indicate a significant advancement in the treatment of relapsed multiple myeloma. The results from the MajesTEC-3 study reveal that a combination therapy using teclistamab and daratumumab can improve survival rates for patients whose cancer has either returned or failed to respond to prior treatments.
The study demonstrated that patients who received this combination therapy experienced a notable extension in the duration of survival without disease progression. Specifically, the data showed a marked increase in the median progression-free survival, demonstrating the potential effectiveness of this dual approach in managing a challenging form of cancer.
Details from the MajesTEC-3 Study
The MajesTEC-3 study involved a diverse group of participants diagnosed with multiple myeloma, a type of blood cancer. Researchers found that administering teclistamab in conjunction with daratumumab led to a significant improvement in health outcomes. The combination therapy allowed patients to remain free from disease progression for an extended period compared to those treated with standard methods.
The results are particularly promising for those with limited options due to relapsed disease. The average duration of treatment before disease progression was observed to be considerably longer among patients receiving the combined therapy, marking a pivotal shift in treatment paradigms for multiple myeloma.
Implications for Future Treatment Options
These findings may reshape the landscape of multiple myeloma treatment, offering hope to patients and healthcare providers alike. The improved efficacy of combining teclistamab with daratumumab could lead to broader adoption of this therapeutic strategy in clinical practice, potentially changing the standard care protocols for relapsed myeloma.
As researchers analyze the implications of these results, the healthcare community is encouraged to consider the benefits of combination therapies in treating complex cancers. The data from the MajesTEC-3 study underscores the importance of continued innovation in cancer treatment, as well as the need for further clinical trials to establish long-term outcomes and safety profiles.
In conclusion, the advancements highlighted at the American Society of Hematology conference represent a meaningful step forward in the fight against multiple myeloma. The combination of teclistamab and daratumumab may soon offer new avenues for patients seeking effective treatment options, reinforcing the ongoing commitment to improving survival rates and quality of life for those affected by this challenging disease.